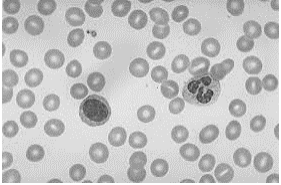
enunciado 564233-1

Foram encontradas 400 questões.
Leia o texto abaixo para responder a questão.
A fase pré-analítica compreende a atenção para com o paciente e o cuidado com os procedimentos para obtenção do material/amostra, que são formas de garantir a qualidade no laboratório. É composta pelas etapas: pedido do exame, preparação do paciente, coleta, transporte e preparo da amostra para posterior análise.
Pesquisas afirmam que cerca de 70% dos erros que acontecem em laboratórios clínicos ocorrem na fase pré-analítica. Sabe-se que esses erros podem ser minimizados se os profissionais estiverem comprometidos e atentos com os procedimentos.
Provas
Leia o texto abaixo para responder a questão.
A fase pré-analítica compreende a atenção para com o paciente e o cuidado com os procedimentos para obtenção do material/amostra, que são formas de garantir a qualidade no laboratório. É composta pelas etapas: pedido do exame, preparação do paciente, coleta, transporte e preparo da amostra para posterior análise.
Pesquisas afirmam que cerca de 70% dos erros que acontecem em laboratórios clínicos ocorrem na fase pré-analítica. Sabe-se que esses erros podem ser minimizados se os profissionais estiverem comprometidos e atentos com os procedimentos.
Provas
Provas
Provas
I. Ágar sangue: meio rico não seletivo, diferencial para hemólise. II Ágar Mac Conkey: meio seletivo para Gram negativo e não diferencial. III. Ágar CLED: meio seletivo para Gram negativo e diferencial para a utilização de lactose. IV. Ágar Salmonela-Shigella: meio seletivo para Salmonela e Shigella e diferencial para a utilização de lactose e produção de H2S.
Provas
Provas
Figura: esfregaço sanguíneo.
Figura: esfregaço sanguíneo.
Assinale a alternativa correta.
Provas
Leia o texto a seguir para responder a questão.
O exame parasitológico de fezes (EPF) resume técnicas utilizadas para diagnosticar os parasitos intestinais, por meio da pesquisa das diferentes formas parasitárias que são eliminadas nas fezes. O exame macroscópico permite a verificação da consistência das fezes, do odor, da presença de elementos anormais, como muco ou sangue e de vermes adultos ou partes deles. Já o exame microscópico permite a visualização dos ovos ou larvas de helmintos, cistos, trofozoítos ou oocistos de protozoários.
Ao fazer a análise microscópica, foram encontradas as seguintes formas parasitárias:

Figuras: Cistos e ovos de parasitas intertinais.
Sobre os achados 1, 2, 3, 4 e 5 respectivamente, assinale a alternativa.
Provas
Leia o texto a seguir para responder a questão.
A malária, mundialmente um dos mais sérios
problemas de saúde pública, é uma doença infecciosa
vetorial causada por protozoários do gênero
Plasmodium, produzindo febre, além de outros
sintomas. Quatro espécies de plasmódio podem causar
a doença: P. falciparum, P. vivax, P. malariae e P. ovale
(essa, de transmissão natural apenas na África).
Tradicionalmente, o diagnóstico Fda doença é feito pela
visualização microscópica do plasmódio no exame da
gota espessa de sangue. Apesar de a microscopia ser
considerada o padrão-ouro para o diagnóstico e
monitoramento do tratamento da malária, essa técnica
exige pessoal treinado e experiente no exame de
distensões sanguíneas.
Provas
( ) A droga B possui menor eficácia que as demais drogas. ( ) A droga A é menos potente que a droga D. ( ) A eficácia de um fármaco é indicada pela tendência em promover a ativação de seu receptor após se ligar a ele. ( ) As drogas A e D possuem a mesma eficácia.

Assinale a alternativa que apresenta a sequência correta de cima para baixo.
Provas
Caderno Container